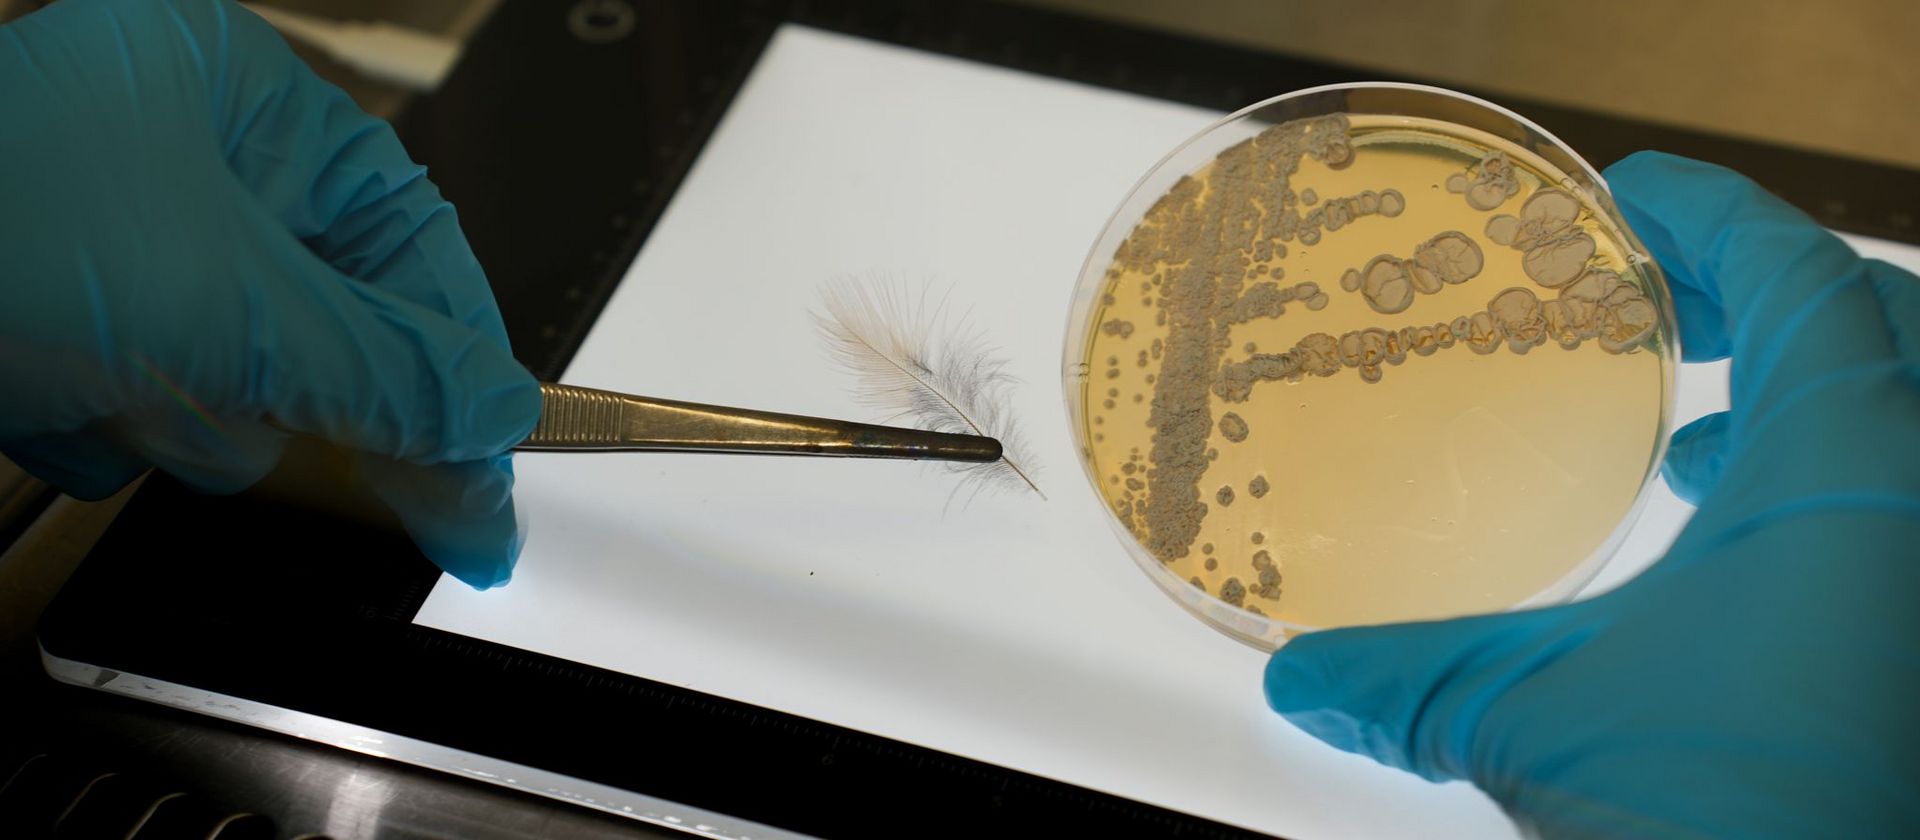

Saarbrücken, 07. Oktober 2024 - Bakterien sind eine wertvolle Quelle für die Entdeckung von Naturstoffen, die für die Entwicklung neuer Medikamente genutzt werden können. Ein Forschungsteam des HIPS konnte aus Bakterien, die in Symbiose mit einem toxischen Vogel leben, nun zwei neue Wirkstoffklassen mit antimikrobiellen Eigenschaften identifizieren. Diese Strategie sowie die entdeckten Substanzen bieten vielversprechende Ansätze für die Entwicklung neuer Anti-Infektiva, insbesondere gegen antibiotikaresistente Krankheitserreger. Ihre Ergebnisse veröffentlichten die Forschenden in der Fachzeitschrift Nature Communications.
Der auf Neuguinea lebende Bergdickkopf, lateinisch Pachycephala schlegelii, ist ein seltsamer Vogel. In seinem schwarz-gelben Gefieder trägt er Batrachotoxin: ein potentes Nervengift, das auch Pfeilgiftfrösche nutzen, um sich effektiv vor Fressfeinden zu schützen. Dieses Toxin wird von den Vögeln nicht selbst produziert, sondern aus Insekten angereichert, die ihnen als Nahrung dienen. Forschende des Helmholtz-Instituts für Pharmazeutische Forschung Saarland (HIPS) haben nun gemeinsam mit internationalen Partnern herausgefunden, dass das Gefieder des Bergdickkopfes mit weiteren Substanzen versehen ist, die ihn vor einem Befall mit unerwünschten Mikroorganismen schützen. Im Gegensatz zu Batrachotoxin werden diese Substanzen jedoch nicht mit der Nahrung aufgenommen, sondern von Bakterien produziert, die mit dem Bergdickkopf in Symbiose leben.
Ein internationales Team um Christine Beemelmanns, HIPS-Abteilungsleiterin und Professorin für Medizinisch-Pharmazeutische Mikrobiotaforschung an der Universität des Saarlandes, isolierte diese Bakterien der Gattung Amycolatopsis aus den Sekreten der sogenannten Bürzeldrüse, einer Hautdrüse des Vogels. In diesen Bakterien konnten die Forschenden bislang unbekannte bioaktive Substanzen entdecken, darunter zwei neue Klassen von Naturstoffen: die Pachycephalamide und Demiguisine. „Die Entdeckung dieser bislang unbekannten Strukturen aus dem Mikrobiom eines Vogels verdeutlicht das enorme Potenzial, das symbiotische Beziehungen für die Identifizierung neuer Naturstoffe bieten“, erklärt die Erstautorin der Studie, Elena Seibel. „Wo unterschiedliche Organismen zusammenleben, kommt es immer zu Interaktionen. Im Fall von Mikroorganismen findet diese Kommunikation mithilfe chemischer Signale statt.“ Auf diese Weise entdeckte Naturstoffe helfen nicht nur dabei, die Interaktion zwischen zwei Organismen besser zu verstehen, sondern können auch zur Entwicklung neuer Anti-Infektiva beitragen.
Dieser innovative Ansatz, bei dem mikrobielle Communities (auch als Mikrobiota bezeichnet) als Quelle neuer Wirkstoffe dienen, ist ein Schwerpunkt von Christine Beemelmanns. Gemeinsam mit ihrem Team arbeitet sie an der Entdeckung und funktionellen Analyse neuer anti-infektiver Naturstoffe aus Mikrobiota. Mithilfe von Ko-Kultivierungsstudien und zellbasierten Assays konnten die Forschenden zeigen, dass die von den Bakterien in der Bürzeldrüse produzierten Substanzen eine antimikrobielle Wirkung haben. Insbesondere wirken die neuen Verbindungen gegen keratinolytische Bakterien und Pilze, die die Haut und Federn von Vögeln angreifen.
„Unsere Arbeit zeigt eindrucksvoll, dass die Identifizierung neuer bioaktiver Naturstoffe aus mikrobiellen Gemeinschaften eine vielversprechende Quelle für die Entdeckung innovativer Anti-Infektiva ist“, erklärt Beemelmanns. „Die neu entdeckten Naturstoffe, insbesondere die Lipopeptide und Hexapeptide, die wir in den Vogelmikrobiomen gefunden haben, bieten ein großes Potenzial zur Bekämpfung von Infektionskrankheiten.“
Durch eine Kombination aus genetischen und Strukturanalysen konnte das Team die genetischen Baupläne entschlüsseln, die für die Produktion dieser Naturstoffe verantwortlich sind und so ihren Ursprung in der symbiotischen Beziehung zwischen Vogel und Bakterium bestätigen. Die Identifizierung solcher Naturstoffe hat weitreichende Bedeutung, insbesondere im Hinblick auf die zunehmende Ausbreitung antimikrobieller Resistenzen, die die moderne Medizin vor eine ernstzunehmende Herausforderung stellen. „Indem wir das Potenzial von Mikroorganismen in symbiotischen Gemeinschaften erschließen, können wir neue therapeutische Ansätze zur Bekämpfung von Infektionen entwickeln und der globalen Resistenzproblematik entgegentreten“, sagt Beemelmanns.
Originalpublikation
Seibel, E., Um, S., Bodawatta, K.H. et al. Bacteria from the Amycolatopsis genus associated with a toxic bird secrete protective secondary metabolites. Nat Commun 15, 8524 (2024). DOI: 10.1038/s41467-024-52316-3

![[Translate to German:] Alexandra K. Kiemer, Simon Both, Martin Empting](/fileadmin/HIPS/__processed__/c/6/csm_Kiemer_Both_Empting_7700535100.jpg)

















![[Translate to English:] Illustration](/fileadmin/HIPS/__processed__/b/6/csm_WebNews_DataLeakage_53fd0ef4a5.png)

































![[Translate to German:] [Translate to German:]](/fileadmin/HIPS/__processed__/c/9/csm_HZI_wiss_hemmhof_mik_001_611abc3df4.jpg)




![[Translate to German:] [Translate to German:]](/fileadmin/HIPS/__processed__/1/b/csm_Andreas_Keller_2023_org_029c5088c1.jpg)

![[Translate to German:] [Translate to German:]](/fileadmin/HIPS/__processed__/b/3/csm_AufDiePlaetze_WID-8615_4ee837e55b.jpg)

![[Translate to German:] Künstliche Intelligenz unterstützt die Entdeckung von Arzneimitteln aus Naturstoffen](/fileadmin/HIOH/News/AI_in_NP_Drug_Discovery_AdobeStock.jpg)
































![[Translate to Deutsch:] [Translate to Deutsch:]](/fileadmin/HIPS/__processed__/2/b/csm_HZI_wiss_pseudomonas_cpi_hzi_001_62730ae12d.jpg)

















